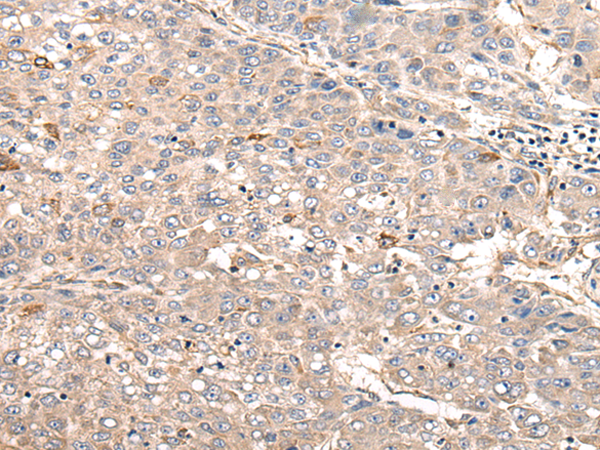
一抗

中文名稱: 兔抗MYLK多克隆抗體
英文名稱: Anti-MYLK rabbit polyclonal antibody
別 名: KRP; AAT7; MLCK; MLCK1; MYLK1; smMLCK; MLCK108; MLCK210; MSTP083
相關(guān)類別: 一抗
儲 存: 冷凍(-20℃) 避光
宿 主: Rabbit
抗 原: MYLK
反應(yīng)種屬: Human
標(biāo) 記 物: Unconjugate
克隆類型: Unconjugate
技術(shù)規(guī)格
|
Background: |
This gene, a muscle member of the immunoglobulin gene superfamily, encodes myosin light chain kinase which is a calcium/calmodulin dependent enzyme. This kinase phosphorylates myosin regulatory light chains to facilitate myosin interaction with actin filaments to produce contractile activity. This gene encodes both smooth muscle and nonmuscle isoforms. In addition, using a separate promoter in an intron in the 3' region, it encodes telokin, a small protein identical in sequence to the C-terminus of myosin light chain kinase, that is independently expressed in smooth muscle and functions to stabilize unphosphorylated myosin filaments. A pseudogene is located on the p arm of chromosome 3. Four transcript variants that produce four isoforms of the calcium/calmodulin dependent enzyme have been identified as well as two transcripts that produce two isoforms of telokin. Additional variants have been identified but lack full length transcripts. |
|
Applications: |
WB |
|
Name of antibody: |
MYLK |
|
Immunogen: |
Synthesized peptide derived from internal of human MYLK. |
|
Full name: |
myosin light chain kinase |
|
Synonyms: |
KRP; AAT7; MLCK; MLCK1; MYLK1; smMLCK; MLCK108; MLCK210; MSTP083 |
|
SwissProt: |
Q15746 |
|
WB Predicted band size: |
211 kDa |
|
WB Positive control: |
HepG2 cells lysate |
|
WB Recommended dilution: |
500-3000 |


 購物車
購物車 幫助
幫助
 021-54845833/15800441009
021-54845833/15800441009